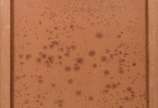
Salvador Dalí (1904-1989), Sem título - Gravura - tiragem 145/250.

Lotes relacionados
-
Não vendido
Lote 799 - Ao vivo!
Santos Dumont - Litografia datada de 1901 com certificado da Vanity Fair nº 59601 - Pontos de fungos.
35 x 24 cm -
Lote arrematado
Lote 905 - Ao vivo!
Sete gravuras diversas, sendo quatro de "Pinelli", pequenos pontos de fungo e uma delas com vidro quebrado.
17 x 23 cm -
Lote arrematado

Lote 803 - Ao vivo!
Duas gravuras de caçada inglesa.
24 x 70 cm -
Não vendido
Lote 831 - Ao vivo!
Par de antigos mapas geográficos.
60 x 80 cm / 56 x 70 cm -
Lote arrematado

Lote 924 - Ao vivo!
Gravura. Com pontos de fungo.
16 x 14 cm -
Lote arrematado

Lote 711 - Ao vivo!
Papiro - Egipcio.
35 x 40 cm -
Não vendido
Lote 926 - Ao vivo!
Dois quadros de celulose com cenas galantes.
5 x 8 cm -
Lote arrematado
Lote 1003 - Ao vivo!
Duas gravuras. "La comparaison des petits pieds" por L.Boilly; e, "Veduta di Piazza Navona". Pequenos pontos de fungo.
40 x 34 cm / 54 x 34 cm -
Não vendido
Lote 396 - Ao vivo!
Óleo sobre tela - assinado - datado 2000
140 x 160 cm -
Lote arrematado
Lote 364 - Ao vivo!
Gravura P.A. Com selo da Galeria Contorno no verso.
56 x 74 cm -
Lote arrematado
Lote 785 - Ao vivo!
Óleo sobre tela. Datado 1986.
44 x 43 cm -
Lote arrematado
Lote 73 - Ao vivo!
Óleo sobre tela. Datado 1952.
65 x 92 cm -
Lote arrematado
Lote 424 - Ao vivo!
Óleo sobre tela - datado 1958.
30 x 43 cm -
Não vendido
Lote 104 - Ao vivo!
Óleo sobre madeira. Tinta soltando em pequenas partes, precisando de restauro.
25 x 33 cm -
Lote arrematado

Lote 534 - Ao vivo!
Óleo sobre tela.
20 x 60 cm